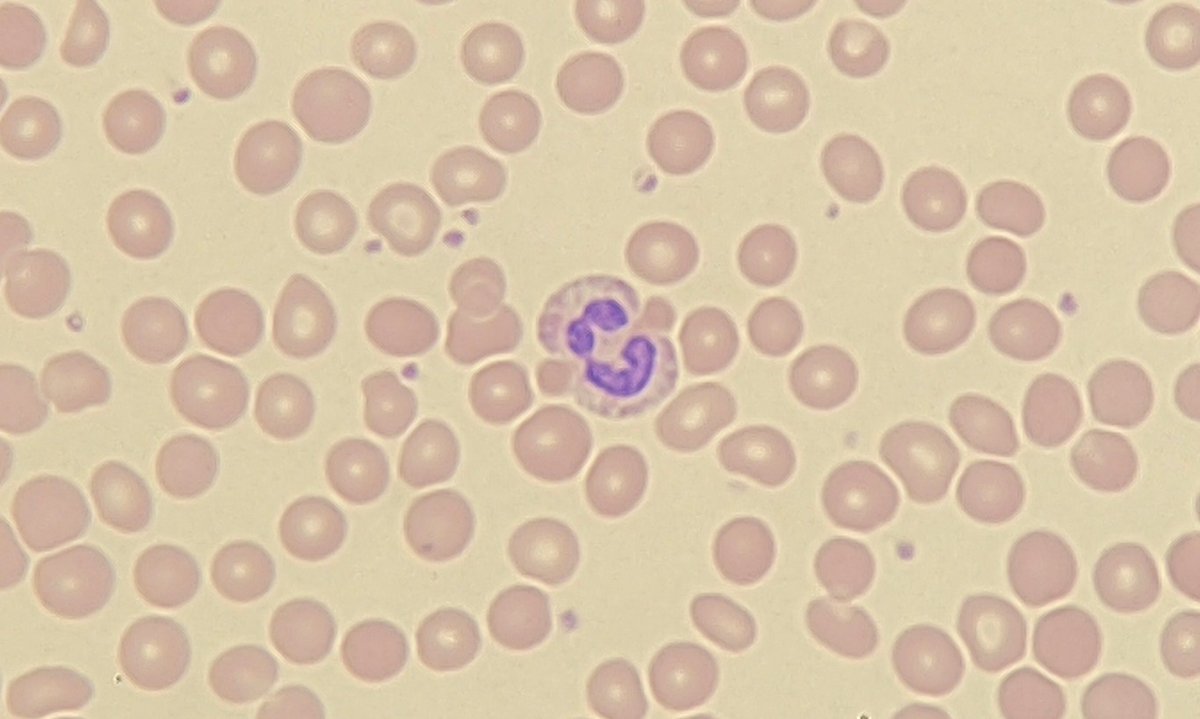
#FilmFriday

Before coffee.     vs     After coffee. 

It's that time of the week.

#OnlyCells #neutrophilsareamood

Gina Sangha
@ginasangha
Haematology Academic Clinical Fellow, Oxford
Clinical Research Trainee, Huntly Lab, Cambridge
ID: 605664085
11-06-2012 19:01:13
44 Tweet
49 Followers
132 Following





In 2016 I looked after a girl who died during a transplant for HbE beta-thalassaemia. I am overwhelmingly pleased that we have been able to correct HbE with near 100% efficiency using base editors. nature.com/articles/s4146… Brilliant work from Mohsin Badat @Montytrench jdavieslab

In older pts with #AML, low-intensity therapy + ven followed by SCT 2-year OS of 72% and lower NRM than intensive chemo. LIT + ven induction is good option even for SCT-eligible pts. Nicholas Short MD MD Anderson Cancer Center #Leukemia doi.org/10.1182/blooda… #leusm


The deadline is fast-approaching - we are seeking an enthusiastic bioinformatician to join us for some great science & a wonderful team of people…. 👇🏼👇🏼👇🏼( RTs appreciated!). Cambridge University Cambridge Stem Cell Institute Haematology at Cambridge

Handy table for counselling patients with AML about allograft options from British Journal of Haematology! Full paper here: onlinelibrary.wiley.com/doi/full/10.11… (open access)

Today, the government’s anti-strike bill returns to Parliament. We must fight back, stand up for workers, and defend our democracy. My piece for Labour Outlook on the #RightToStrike. labouroutlook.org/2023/05/21/whe…



When Matt isn’t around he should be replaced by the Olly Smith and Helen McGinn double act! SaturdayKitchen

Thank you Prof. Dame Sally Davies for saying out loud the things we all want to say!